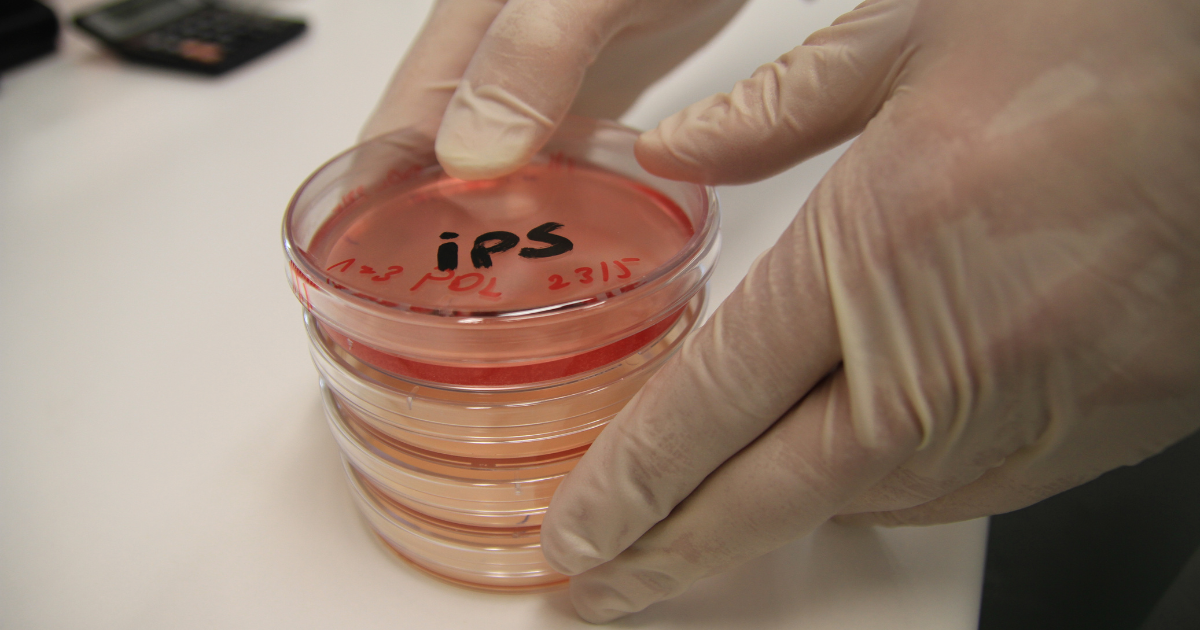
🤖 OpenAI’s New Job Listings Reveal Robotics Roadmap

Embrace seasonal changes with our new openai job listings reveal the company's robotics plans | techcrunch gallery of hundreds of weather-themed images. showcasing weather-dependent computer, digital, and electronic. perfect for seasonal marketing and campaigns. Our new openai job listings reveal the company's robotics plans | techcrunch collection features high-quality images with excellent detail and clarity. Suitable for various applications including web design, social media, personal projects, and digital content creation All new openai job listings reveal the company's robotics plans | techcrunch images are available in high resolution with professional-grade quality, optimized for both digital and print applications, and include comprehensive metadata for easy organization and usage. Explore the versatility of our new openai job listings reveal the company's robotics plans | techcrunch collection for various creative and professional projects. Advanced search capabilities make finding the perfect new openai job listings reveal the company's robotics plans | techcrunch image effortless and efficient. Our new openai job listings reveal the company's robotics plans | techcrunch database continuously expands with fresh, relevant content from skilled photographers. Each image in our new openai job listings reveal the company's robotics plans | techcrunch gallery undergoes rigorous quality assessment before inclusion. Instant download capabilities enable immediate access to chosen new openai job listings reveal the company's robotics plans | techcrunch images.

![Create New OpenAI Project [ 2023 ] - TestingDocs.com](https://www.testingdocs.com/wp-content/uploads/OpenAI-Platform-Signup-or-Login.png)









![Careers at [24]7.ai - Locations, Open Positions & Opportunities](https://www.247.ai/wp-content/uploads/2024/03/Grow-1808605463-min.webp)





